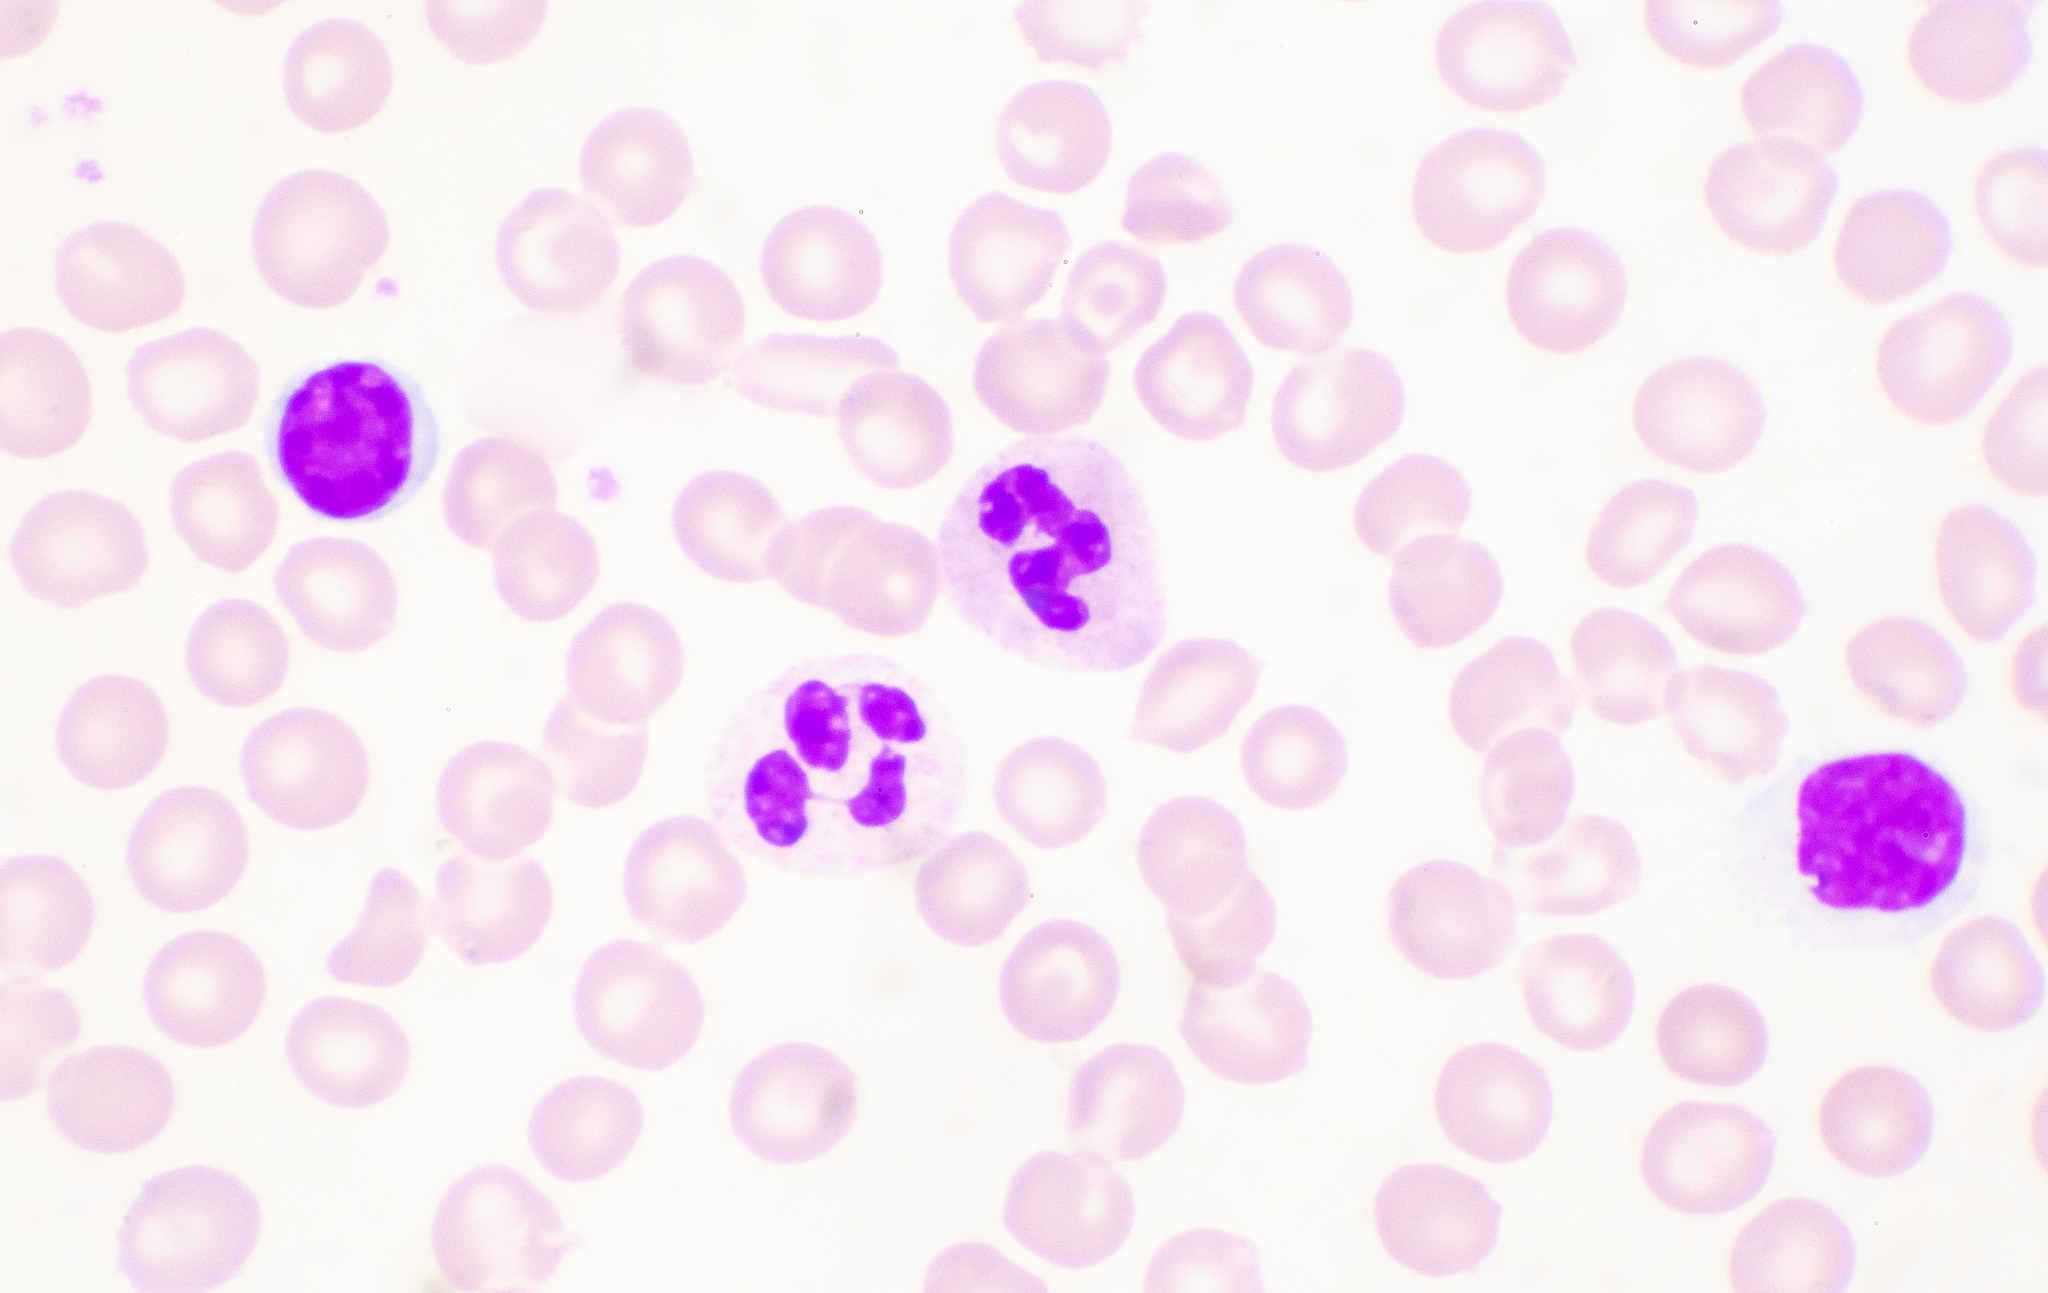
淋巴亚群在血液肿瘤中的应用：分期、预后评估和治疗 - 血液肿瘤诊断治疗新方向

淋巴亚群在血液肿瘤中的应用:分期、预后评估和治疗 - 血液肿瘤诊断治疗新方向
淋巴亚群在血液肿瘤的应用主要体现在以下几个方面:\n\n1. 淋巴亚群用于肿瘤的分期和分级:淋巴亚群是淋巴系统中的一个重要组成部分,肿瘤的扩散常常通过淋巴系统进行。通过检测淋巴亚群中的肿瘤细胞数量和转移情况,可以帮助确定肿瘤的分期和分级,从而指导治疗方案的选择。\n\n2. 淋巴亚群用于肿瘤的预后评估:淋巴亚群中的肿瘤细胞数量和转移情况与肿瘤的预后密切相关。通过检测淋巴亚群中的肿瘤细胞数量和转移情况,可以评估患者的预后,为治疗方案的制定和预后的预测提供参考。\n\n3. 淋巴亚群用于肿瘤的治疗:淋巴亚群可以通过淋巴造影、淋巴细胞移植等技术,用于肿瘤的治疗。例如,在血液肿瘤中,可以通过淋巴亚群的检测和治疗,改善患者的免疫功能,提高治疗效果。\n\n总之,淋巴亚群在血液肿瘤的应用可以帮助医生进行肿瘤的分期和分级、预后评估,以及指导治疗方案的选择和预后的预测。此外,淋巴亚群还可以用于肿瘤的治疗,改善患者的免疫功能,提高治疗效果。
原文地址: https://www.cveoy.top/t/topic/pBF3 著作权归作者所有。请勿转载和采集!